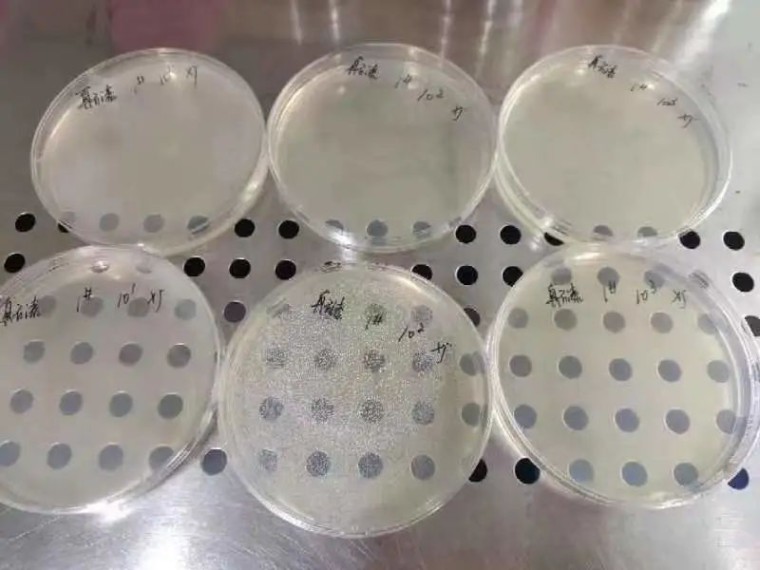
image010

NT-12S是上海鵬圖抗菌新材料有限公司最新研發的一款針對真石漆專用的抗菌劑,具有超高性價比的三合一殺菌防腐抗菌劑,多組份協同增效配合使用,高效廣譜。在真石漆中能有效的殺滅細菌和抑制細菌的生長,在高溫環境下也有優異的防腐作用。

通過有效物殘留測試,對比得出 NT-12S抗菌劑在真石漆55℃熱儲7天后有效物殘留量仍然可以達到最低抑菌濃度,成品真石漆在工地暴曬2-3個月情況下,能防止暴曬高溫導致產品的腐敗變質。





NT-12S抗菌劑樣品檢測報告
進一步實驗表明,真石漆在使用NT-12S抗菌劑后,細菌挑戰28天實驗,可達0級抗菌,每噸真石漆中只需添加2-3公斤,能保證涂料在生產、運輸、儲存期間不會出現腐敗、變質等問題。

真石漆加入NT-12S抗菌劑熱儲實驗
NT-12S抗菌劑在真石漆體系中具有超高的性價比,每噸只需添加2-3公斤,可以達到優異的罐內儲存,并在涂料經過工地室外暴曬的情況下可以有效的防止暴曬高溫惡劣環境下產品的腐敗變質。

NT-12S抗菌劑TDS
上海鵬圖抗菌新材料研發中心成立于2005年,自成立以來不斷開拓研發各項微生物控制技術。目前鵬圖研發中心成功研發出多項針對建筑涂料、工業涂料、公共衛生、造紙、紡織產業、皮革、混凝土外加劑、油墨、日用化學、水處理、膠粘劑、船舶等行業所使用的微生物控制劑。
自鵬圖研發中心成立以來與多所國內高等院校及專業機構進行了多項合作研究,目前依然與上海交通大學、上海工程技術大學、長三角納米研究院、中國涂料工業大學、常州大學、青島海洋研究院、杭州微生物研究所有著多項合作研究。
鵬圖堅持以技術為導向,自組建研發中心以來已建立了龐大的研發團體,目前鵬圖研發中心擁有高級職稱人才8名,碩士及以上人數16名的研發與技術團隊,并擁有業內屈指可數的同時具備涂料、微生物檢測功能的頂級實驗室。

?

分享好友


